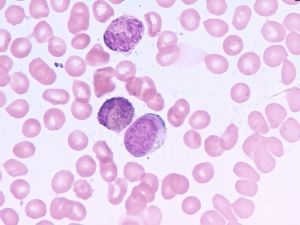
cml

簡介
慢性髓性白血病(CML)是骨髓增生性疾病(MPDS)之一。這些疾病主要是源於造血幹細胞基因缺陷所致。MPDs與成熟和幼稚血細胞異常增高相關,而這可以影響到一個或所有血細胞系統。共同特徵
血液成分(紅細胞前體細胞、血小板前體細胞、髄性前體細胞)在骨髓
cml疾病通過侵襲性逐漸增加的各個臨床期而獲得進展
疾病最終發展到終末期,或者為急變期(急性白血病樣),或者為骨髓纖維化期(骨髓耗竭期)。
MPDs疾病
CML:主要影響粒細胞(髄性細胞)的一種惡性腫瘤真性紅細胞增多症(PV):一種影響紅細胞的惡性腫瘤
血小板異常增多症(ET):影響巨核細胞和血小板的惡性腫瘤
特發性(原因不明的)骨髓纖維化(AMM):一種影響骨髓微環境的惡性腫瘤。
病因學
cml流行病學統計資料顯示,各國CML的發病率相對一致,約為1-2人/10萬。在兒童中,CML的發病率極低,所占比例不超過兒童白血病的5%。成人中,CML占所有成人白血病的15%,比急性髄性白血病、骨髓增生異常綜合徵(AML/MDS)和慢性淋巴細胞白血病(CLL)少見。
CML中位發病年齡為45-55歲。有一半的患者年齡超過60歲。
CML的病因學尚不清楚。
CML的發生與遺傳因素相關的證據極少。CML患者的後代發病率並不比普通人群高,而且在同卵雙生中,CML的發病並無直接聯繫。這些證據有力的支持了CML是一個獲得性疾cml病(而不是遺傳性的)。
CML與接觸放射性照射有某種聯繫(如,日本核子彈爆炸中倖存者可證實這點)。然而是否接受放射治療就會導致CML發生,這點現在還存在爭議。CML和感染之間沒有已知的聯繫。
診斷特徵
CML三個獨特病程進展分期:慢性期
加速期
急變期(也有的醫生稱為原始細胞危象期)
在最初診斷為CML時,大多數患者(85%-90%)處於慢性期。近些年來,有更為早期發現該疾病的趨勢。這些患者中的大部分(某種情況下可能超過50%)在首次檢查時沒有臨床症狀,其診斷主要是依據偶然的實驗室檢查如白細胞計數異常增高(白細胞增多症)。
症狀
當CML患者出現症狀時主要與其高代謝狀態、白細胞計數增多、脾臟腫大有關,包括:疲乏,盜汗。體重減輕,腹部飽滿。慢性期CML實驗室檢查最顯著的特徵為白細胞計數增多,主要為各個階段成熟期狀態的細胞。慢性期CML患者外周血塗片與骨髓穿刺塗片的結果相似。
在白細胞增多的同時,還可以有外周血中血小板計數增加(血小板增多症)、嗜鹼細胞的數量增加(嗜鹼細胞增多症)和嗜酸性細胞數量的增加(嗜酸性細胞增生症),骨髓中的表現也如此。
這張來自正常健康人外周血塗片顯示沒有出現白細胞。偶爾可以見到血小板。白細胞也是偶爾可見的,並且是成熟的中性粒細胞。或者淋巴細胞。不成熟的白細胞不超過其組總量的5%-10%。
嗜鹼細胞增多被認為是CML一個預後不良的特徵,但原因尚不清楚。
在30%-50%的患者中可以觀察到血小板增多,偶爾其總的計數可以超過1,000x109/l。
該病確診時大約有20%的患者出現貧血。
約50%-70%的CML患者白細胞水平超過100x109/l。
約有10%-20%處於慢性期的患者白細胞呈現周期性變化,這或許歸因於儲備的有節律的控制是低水平的。
CML患者骨髓穿刺顯示粒系增生為主,其中明顯存在早期形態的細胞.在活檢時,骨髓呈顯著的細胞過多,伴有髄性細胞(例如白細胞)和紅系細胞的祖細胞的比率增高(M:E比率增高)血液生化學檢查異常,例如乳酸脫氫酶(LDH)升高或者尿酸水平的升高。這些異常反映血細胞的更新很快。
骨髓穿刺塗片與外周血塗片極其相似。骨髓穿刺塗片顯示出各個階段成熟期狀態下的大量粒細胞(髄性細胞),同時也有早期細胞,如中幼粒細胞(M)和早幼粒細胞(P)。髄系和紅系細胞的比率(M:E)明顯增加。
低倍鏡下,顯示骨髓細胞多形性增加,脂肪細胞缺乏。高倍鏡下,可以看到大多數細胞為髄性細胞。在慢性期基本沒有纖維化的證據,但是隨著疾病的進展,骨髓組織被疤痕組織取代或纖維化非常明顯。和正常的塗片比較。
正常比例的脂肪細胞(透明區域)和其他組織成分呈均衡分布。高倍鏡下可以看到各種類型的細胞均存在。圖4和5中塗片顏色的不同是因為染色技術的不同,並非是骨髓的異常。
評價
當患者持續表現為不能解釋的白細胞增多和/或脾臟腫大時,就要懷疑CML。此時,要檢查全血細胞計數以及細胞分型和血小板計數。骨髓穿刺、活檢是確定原始血細胞和嗜鹼性細胞比例、評價骨髓纖維化程度以及為獲得正確細胞遺傳分子學分析及診斷所必須的檢查。或許在醫學記錄和文獻有白細胞鹼性磷酸酶(LAP)的檢測,但是現在已經被基因檢測所廣泛代替。目前,CML的診斷依據是:基因分析發現費城染色體( Ph )。
Ph染色體是一組異常的小的G組染色體,因在費城首次發現該染色體而命名。
1960年,賓夕法尼亞大學的Peter Nowell以及癌症研究學院的David Hungerford報導了與7例CML患者相關的“一個微小的染色體…取代了四條最小常染色體中的一條。
隨後的研究確認了該染色體(Ph染色體)在CML中是非常常見的,但在其他疾病中罕見。
在1970年早期,隨著染色體分析技術的出現,使Ph染色體的進一步分析成為可能。最早顯示出異常的小的Ph染色體是一個22號染色體,確切的說是其長臂(q)的丟失。1973年,Janet Rowley描述了該染色體即22號染色體丟失的部分易位到(轉移)9號染色體上(9+)。實際上幾乎所有CML患者(90%到95%)都有Ph染色體,並且該染色體的存在被用於CML診斷及治療後隨訪。
此外,約有10%的患者具有CML血液學和臨床特徵,但是沒有Ph染色體或者細胞遺傳學的特點。套用敏感性更高的分子生物學檢測技術,如FISH或PCR,這些患者中的1/3-1/2可以檢測到異常基因陽性或者與染色體相關的異常蛋白陽性。這些患者的預後和治療反應與Ph(+)的CML患者相似。在其餘的患者中,目前的研究結果或者陰性或者不能使用,所以其診斷也是不確定的。
其他診斷
其他骨髓增生性疾病——原發性骨髓纖維化
——真性紅細胞增多症
——原發性血小板增多症
非典型的CML-費城染色體陰性和Bcr-Abl陰性的骨髓增生性疾病(下面的討論將解釋Bcr-Abl)患者的預後較Ph(+)的CML患者差。
慢性中性粒細胞白血病——是一種罕見的疾病,異常克隆主要局限於中性粒細胞的前體細胞;臨床過程是異基因的,但是其特徵性表現為穩定持久的、成熟的嗜中性粒細胞增多、血小板增多以及緩慢的病情進展,很少發展到急變期。
慢性粒-單核細胞白血病——是骨髓異常綜合徵的一種,臨床上與CML相似,但是Ph染色體陰性。
青少年慢性髓性白血病——是兒童中罕見的Ph(-)白血病,白細胞計數與CML相似,但是臨床過程上更傾向於AML(急性髓性白血病)。
類白血病反應——其白細胞的顯著增加並不是因為血液學方面的惡性腫瘤,而常常是因為沒有診斷的炎症過程或毒性反應,偶爾也可能是一個實體惡性腫瘤所引起的。
自然病程
CML的典型臨床發展過程要通過三個階段或者“三期6”。常規化療能夠延長患者生存期,但是不能改變疾病進展過程。大多數處於慢性期的患者都可以進展到加速期(然而也有一些患者可以跳過該期),接下來在進入短暫的急變期之後不久將死亡。各個階段發展時間持續的情況可以被傳統的化療改變,但是並不影響各個分期臨床過程的發展。
最初診斷時,絕大多數CML患者都處於慢性期(也被認為CML的惰性期)。慢性期持續的時間不一,平均約為5-6年。即使通過化療,CML仍然可以進展到加速期,通常加速期持續6-9個月之後,會發展到急變期。偶爾可以不經過加速期直接由慢性期轉化為急變期。CML各期的臨床標準見表格1。
表格1.CML各期的臨床標準
慢性期
加速期
急變期
白細胞
≥20x109/l
原始血細胞
<15%
15%-30%
>30%
嗜鹼性細胞
≥20%
血小板
正常or
骨髓細胞多形性
染色體
Ph+
Ph+
Ph+
該表加速期的標準採用諾華公司臨床研究中所用的標準
慢性期CML的定義相對直接:患者的白細胞數增高,粒細胞處於各個階段的成熟期,在外周血和骨髓中原始粒細胞的比率小於15%。
急變期是指外周血或者骨髓中的原始血細胞的比率超過30%,而且伴有白血病細胞的組織浸潤,這些組織主要是淋巴結、皮膚、皮下組織、骨或者中樞神經系統(如綠色瘤)。
單獨通過顯微鏡下的表現很難判斷急變期的各細胞系。免疫學研究已經表明,大多數處於急變期的患者細胞與AML(急性髓性白血病)的原始粒細胞相似。這是一個重要的特徵,因為少數患者的細胞與ALL(急性淋巴細胞白血病)細胞相似,因此對ALL治療有效,並且這些患者的預後較其他組好。
基於免疫學研究,大約1/2急變期的CML患者的異常細胞顯示同白細胞系相一致的標誌物(例如AML急性髓性白血病)。大約1/4的患者的細胞類型與ALL細胞的免疫標誌物相一致。餘下的患者體內的細胞或者沒有特異的細胞抗原,或者為罕見的細胞形態(巨核細胞、紅細胞、嗜鹼性細胞)。這一特徵是非常重要的,因為25%與ALL原始細胞相似的患者,套用ALL治療方案有效,而且其預後比其他組好。
加速期CML在某種程度上是很難定義的一個轉換時期。常用的定義加速期CML的標準反映了其對治療耐藥性的增加,以及在治療時疾病仍然進展。
加速期難以定義的特徵可能會導致對臨床結果的爭論,即在一些治療小組報導其治療處在“加速期”患者的療效優於其他治療組時,而其他治療組將這些患者認為是慢性期CML患者。M.D.Anderson治療小組通過多變數分析以及相關生存期1.5年的來嚴格定義加速期。疾病處於加速期的另外一個臨床特徵是出現其他染色體異常的表現(即所謂的細胞遺傳學或者克隆演化)。
描述
在CMMB(中國移動多媒體廣播)中,CML(CMMB Markup Language)表示CMMB可擴展描述語言在資本資產定價模型中,CML為資本市場線(capital market line,CML)的簡稱,也叫權衡取捨線。
是無風險證券的收益率R0,坐標(0,R0),與最小方差資產組合雙曲線:σ^2=A/Δ*(a-Β/Α)+1/Α上的點的連線。
當直線過點(0,R0)與有效前沿相切時,夏普比(a-R0)σ(表示承擔每一單位的風險所得到的超額回報)達到最大值。理性的投資者必然會選擇單位風險回報最大的投資組合。一部分資金會投放在無風險證券上,一部風資金會投放在過點(0,R0)並與有效前沿相切的直線所代表的資產組合。)
治療形式
1.干擾素2.化療
3.酪氨酸激酶抑制劑(達沙替尼,伊馬替尼等)
4.放療
5.骨髓移植
6.其他治療。
預後
目前尚無可靠的預測方法,但是大量研究證實:年齡、脾臟大小、血小板計數、外周血或骨髓中原始細胞比例、嗜鹼性粒細胞比例均為影響預後的因素。1984年Sokal提出一個預測危險比率(riskratio,RR)的公式,以年齡(年)、脾(肋中線下cm)、血小板數(109/L)及血中原粒細胞數(%)為變數。公式如下:RR={0.0116(年齡-43.4)+0.0345(脾-7.51)+0.188[(血小板數/700)2-0.563]+0.087(原粒-2.10)}
RR<0.8為低危,RR<0.8~1.2為中危,RR>1.2為高危。有資料表明低危組中位存活期為60個月,中危組為46個月,高危組32個月。但是對於接受IFN治療的患者,此公式的判斷結果不肯定,而對IFN治療的反應則是影響預後的重要因素。
發病機制
1.起源於造血幹細胞CML是一種起源於造血幹細胞的獲得性克隆性疾病,其主要證據有:①CML慢性期可有紅細胞、中性粒細胞、嗜酸/嗜鹼粒細胞、單核細胞和血小板增多;②CML患者的紅系細胞、中性粒細胞、嗜酸/嗜鹼粒細胞、巨噬細胞和巨核細胞均有Ph染色體;③在G-6-PD雜合子女性CML患者中,紅細胞、中性粒細胞、嗜酸/嗜鹼粒細胞、單核細胞和血小板表達同一種G-6-PD同工酶,而成纖維細胞或其他體細胞則可檢測到兩種G-6-PD同工酶;④每個被分析的細胞其9或22號染色體結構異常都一致;⑤分子生物學研究22號染色體斷裂點變異僅存在於不同CML患者,而在同一病人的不同細胞中其斷裂點是一致的;⑥套用X-連鎖基因位點多態性及滅活式樣分析亦證實了CML為單克隆造血。
2.祖細胞功能異常相對成熟的髓系祖細胞存在有明顯的細胞動力學異常,裂指數低、處於DNA合成期的細胞少,細胞周期延長、核漿發育不平衡,成熟粒細胞半衰期比正常粒細胞延長。採用3H自殺試驗證實僅只有20%的CML集落處於DNA合成期,而正常人為40%,CML原粒、早幼粒細胞標記指數比正常人低,而中、晚幼粒細胞標記指數與正常對照相比無明顯差別。造血祖細胞集落培養發現CML骨髓祖細胞與外周血祖細胞的增殖能力不同,骨髓CFU-GM和BFU-E數與正常對照相比通常增高,但亦可正常或減低,而外周血可升高至正常對照的100倍。Ph陽性CML病人骨髓細胞長期培養研究發現,經幾周培養後在培養基中可檢測到Ph陰性的祖細胞,現已證實這主要為CML造血祖細胞黏附功能異常所致。
3.分子病理學1960年,Nowell和Hungerfor描述了CML相關的Ph染色體,這是首次發現的與一特異人類腫瘤相關的非隨機染色體異常。1973年Rowley採用奎寧和姬姆薩染色技術首次證實CML中發現的Ph染色體(22q-異常)是t(9;22)(q34;q11)染色體易位所致。1982年在9q34斷裂區克隆出了ABL基因。1983年證實位於q34的基因片段易位到22號染色體上與22q11斷裂區一個稱為BCR的基因形成BCR-ABL融合基因。
(1)ABL基因:原癌基因c-abl定位於q34,在物種發育過程中高度保守,編碼在所有哺乳動物組織和各種類型細胞中均普遍表達的一個蛋白質,c-abl長約230kb,含有11個外顯子,走向為5′端至著絲粒。該基因第一個外顯子有兩種形式,外顯子1a和1b,因而有兩種不同的c-ablmRNA,第一種稱為1a-11,長6kb,包括外顯子1a-11;另一種稱為1b,自外顯子1b開始、跨越外顯子1a和第一個內含子,同外顯子2-11相接,長為6kb,這兩種ABL的RNA轉錄編碼兩種不同的分子量均為145000的ABL蛋白。DNA序列分析發現。c-abl屬非受體蛋白-酪氨酸激酶家族,除激酶片斷外,該基因還有在信號傳導蛋白的相互作用和調節中非常重要的SH2和SH3片斷,c-abl的特徵是有一個大的C末端非催化片斷,該片斷含有DNA和細胞骨架結合的重要序列和一個參與該傳導信號的區域。正常的p145ABL穿梭於細胞核和胞漿之間,主要定位於細胞核,具有較低的酪氨酸激酶活性。p145ABL的活性和細胞內定位受連線細胞骨架與細胞外間質的整合素(integrins)調控,現有研究表明至少在纖維細胞,ABL激活需要細胞黏附,因此ABL可能通過將整合素信號傳遞至細胞核從而充當黏附和細胞周期信號之間的橋樑,參與細胞生長和分化控制。
(2)BCR基因:BCR基因定位於22q11,長130kb,有21個外顯子,起始方向5′端至中心粒。有4.5kb和6.7kb兩種不同的BCRmRNA轉錄方式,編碼一分子量為160000的蛋白p160BCR,該蛋白有激酶活性。p160BCR之C末端與ras相關的GTP結合蛋白p21的GTP活性有關聯。
(3)BCR-ABL基因:位於9q34的c-abl基因易位於22號染色體與位於22q11的bcr基因形成BCR-ABL融合基因。迄今CML患者中已發現有3個bcr斷裂點叢集區,分別為M-bcr、m-bcr、u-bcl和6種BCR-ABL融合轉錄方式,與M-bcr相應的有b2a2、b3a2、b2a3,其編碼蛋白為p210,與m-bcr相應的有ela2,其編碼蛋白為p190,與u-bcr相應的有e19a2,其編碼蛋白為p230。
小鼠模型體內已證實BCR-ABL可導致CML發生,BCR-ABL融合蛋白定位於細胞漿,具有極高的酪氨酸激酶活性,通過改變作為BCR-ABL催化底物的一些關鍵的調節蛋白磷酸化狀況激活多種信號傳導途徑,如通過激活參與細胞增殖和分化調控的Ras信號途徑,使祖細胞數量增多,幹細胞池減少,幹細胞成為增殖池的一部分,從而使未成熟粒細胞不斷擴增。BCR-ABL作用的另一種機制是改變正常整合素功能,正常造血祖細胞黏附於細胞外基質,而黏附是由祖細胞細胞表面受體特別是整合素來介導的,BCR-ABL通過干擾β1整合素的功能導致CML細胞的細胞黏附功能缺陷,從而使未成熟細胞釋放至外周血並遷移至髓外部位。
最近,CML發病機制研究又取得了進展:①體外培養發現,BCR-ABL通過抑制凋亡而延長CML祖細胞的因子非依賴性生長時間;②用反義寡核苷酸下調BCR-ABL表達後可能通過增加細胞對凋亡的敏感性從而抑制白血病細胞在小鼠體內生長,特別是減少CML病人早期祖細胞集落形成,降低CML樣細胞系的細胞增殖;③表達BCR-ABL的、轉化的、因子非依賴性的、可致瘤的小鼠造血細胞通過上調bcl-2而增加對凋亡的敏感性,當bcl-2表達受抑後,BCR-ABL陽性細胞又變成了因子依賴性和非致瘤性。以上實驗結果表明,BCR-ABL抑制細胞凋亡導致髓系細胞不斷擴增是CML的又一發病機制。
(4)急變發生機制:細胞遺傳學研究發現80%的AP或BPCML患者有繼發性染色體異常,最常見的異常依次為+8、+Ph、i(17)、+19、+21和-Y。急性粒細胞白血病變(急粒變)的患者中約80%有非隨機性染色體異常,其染色體核型常表現為超二倍體,最常見的異常為+8,且+8常與其他染色體異常如i(17)、+Ph、+19等同時出現,其次為+Ph、i(17)和-Y。急性淋巴細胞白血病變(急淋變)的患者約30%有繼發性克隆性染色體異常,常為染色體丟失,從而表現為亞二倍體或結構異常,常見異常為+Ph和-Y,+8少見,i(17)尚未見報導,-7、14q+與急淋變特異相關。儘管有研究發現急變期CML有N-Ras基因突變和c-Myc基因表達增高,但其發生率極低。Rb基因在急變期CML患者亦極少有改變。Sill等發現p161NK4A基因的純合子缺失與CML。